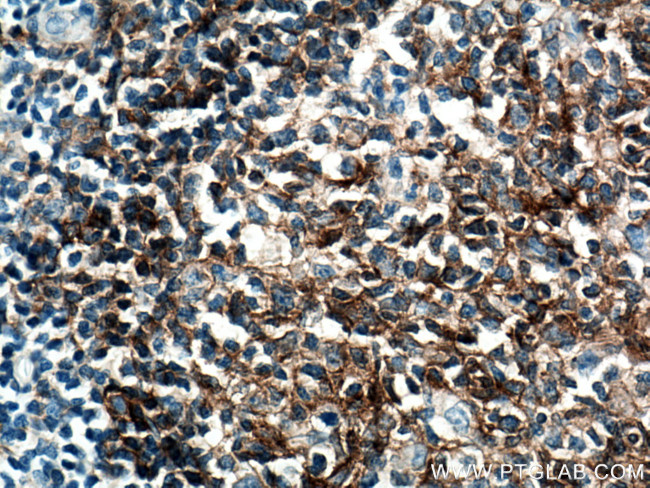
CD40 Antibody in Immunohistochemistry (Paraffin) (IHC (P))

Search
Proteintech
CD40 Monoclonal Antibody (2A8G5)
{{$productOrderCtrl.translations['antibody.pdp.commerceCard.promotion.promotions']}}
{{$productOrderCtrl.translations['antibody.pdp.commerceCard.promotion.viewpromo']}}
{{$productOrderCtrl.translations['antibody.pdp.commerceCard.promotion.promocode']}}: {{promo.promoCode}} {{promo.promoTitle}} {{promo.promoDescription}}. {{$productOrderCtrl.translations['antibody.pdp.commerceCard.promotion.learnmore']}}
产品信息
66965-1-IG
种属反应
宿主/亚型
分类
类型
克隆号
抗原
偶联物
形式
浓度
规格
纯化类型
保存液
内含物
保存条件
运输条件
产品详细信息
Aliquoting is unnecessary for -20°C storage.
靶标信息
CD40 is a single-chain glycoprotein and a member of the tumor necrosis factor receptor (TNFR) family, exhibiting significant homology to the Hodgkin's disease-associated antigen, CD30. It is expressed by B lymphocytes, follicular dendritic cells, thymic epithelium, and a subset of peripheral T cells, as well as some epithelial cells, carcinomas, and lymphoid dendritic cells. Notably, CD40 is present on all B cells except plasma cells. CD40 plays a crucial role in regulating B cell development and maturation, inducing immunoglobulin isotype-switching, and protecting B cells from surface Ig-induced apoptosis when combined with other signals such as IL-4. It promotes proliferation and is essential for T cell-dependent immunoglobulin class switching, memory B cell development, and germinal center formation. The interaction between CD40 and its ligand CD154 (gp39) on T cells is vital for T-B cell crosstalk, costimulation, and immune regulation. Adaptor protein TNFR2 interacts with CD40, mediating signal transduction, while the AT-hook transcription factor AKNA is reported to regulate CD40 expression, which may be important for homotypic cell interactions. Additionally, the interaction between CD40 and its ligand is necessary for amyloid-beta-induced microglial activation, suggesting a role in the early pathogenesis of Alzheimer's disease. Two alternatively spliced transcript variants encoding distinct isoforms of CD40 have been identified. Diseases associated with CD40 dysfunction include Type 3 Hyper-IgM immunodeficiency and CD40 ligand deficiency, highlighting its importance in immune and inflammatory responses.
仅用于科研。不用于诊断过程。未经明确授权不得转售。
篇参考文献 (0)
生物信息学
蛋白别名: B cell surface antigen CD40; B cell-associated molecule; B-cell surface antigen CD40; Bp50; CD antigen CD40; CD40; CD40 molecule, TNF receptor superfamily member 5; CD40L receptor; CDw40; Immunoglobulin M; ImmunoglobulinM; MGC9013; sCD40; soluble CD40; Tumor necrosis factor receptor superfamily member 5
基因别名: Bp50; CD40; CDW40; p50; TNFRSF5
UniProt ID: (Human) P25942
Entrez Gene ID: (Human) 958